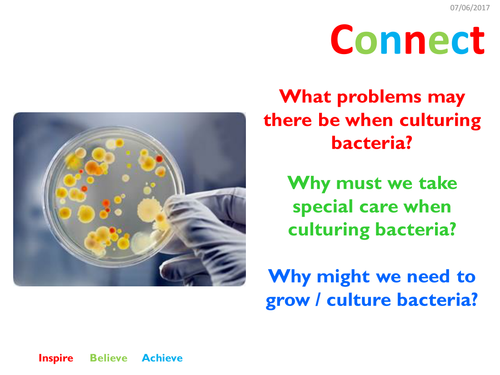
pptx, 2.27 MB

2 lessons on aseptic technique and includes elements of the required practical. The lessons are split into the 4 part structure.
Something went wrong, please try again later.
This resource hasn't been reviewed yet
To ensure quality for our reviews, only customers who have purchased this resource can review it
Report this resourceto let us know if it violates our terms and conditions.
Our customer service team will review your report and will be in touch.
£1.00
